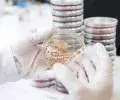

- Accueil
- Chercher 2024
- Culture de minitumeurs pour mieux soigner le cancer du poumon
Culture de minitumeurs pour mieux soigner le cancer du poumon
C’est une avancée majeure dans la lutte contre le cancer du poumon qui a vu le jour grâce aux HUG et à l’Université de Genève (UNIGE). Pour la première fois, des chercheurs et chercheuses ont décrit précisément une méthode permettant de cultiver des sphéroïdes tumoraux pulmonaires, à partir de cellules prélevées directement sur les patientes et patients. Ces tumeurs miniatures recréent le fonctionnement des cellules cancéreuses et offrent une plateforme unique pour tester rapidement divers traitements anticancéreux. En deux à trois semaines seulement, il devient possible d’identifier les thérapies les plus efficaces pour chaque cas individuel.
Le cancer du poumon, responsable de 20% des décès liés au cancer, est une maladie complexe et hétérogène. Les traitements actuels, tels que la chimiothérapie ou les thérapies ciblées, ne conviennent pas à toutes les tumeurs. La résistance aux médicaments aggrave cette problématique, nécessitant souvent des combinaisons thérapeutiques. Grâce à cette découverte, les chercheurs et chercheuses des HUG et de l’UNIGE peuvent désormais tester les réactions des tumeurs dans des conditions proches de la réalité et adapter ainsi les soins aux besoins spécifiques de chaque personne.
Cette étude, dirigée par la Dre Véronique Serre-Beinier, responsable du laboratoire de recherche fondamentale du Service de chirurgie thoracique et endocrinienne des HUG et chercheuse au Département de chirurgie de la Faculté de médecine de l’UNIGE, a inclus des patientes et patients atteints de carcinomes pulmonaires « non à petites cellules ». Les fragments tumoraux collectés lors d’interventions chirurgicales ont été cultivés en sphéroïdes, des agrégats cellulaires en trois dimensions. Ces sphéroïdes servent à évaluer la réponse à divers traitements en moins de vingt jours. Le modèle analyse également la toxicité des médicaments sur des sphéroïdes de tissus sains, réduisant ainsi les risques d’effets secondaires.
Parmi les co-auteurs de cette recherche figurent le Dr Wolfram Karenovics, médecin adjoint au Service de chirurgie thoracique et endocrinienne des HUG, et le Pr Alfredo Addeo, médecin-chef du Service d’oncologie et responsable du Centre du cancer du poumon des HUG, ainsi que professeur ordinaire au Département de médecine de la Faculté de médecine de l’UNIGE.
En anticipant les résistances potentielles des tumeurs aux traitements, cette technique pourrait révolutionner la prise en charge des cancers du poumon. Les premiers résultats ouvrent la voie à une médecine plus individualisée et, à terme, à des thérapies mieux ciblées, évitant aux patients et patientes des traitements inutiles.
En savoir plus : Cancer du poumon : la culture de tumeurs pulmonaires pour trouver le meilleur traitement personnalisé